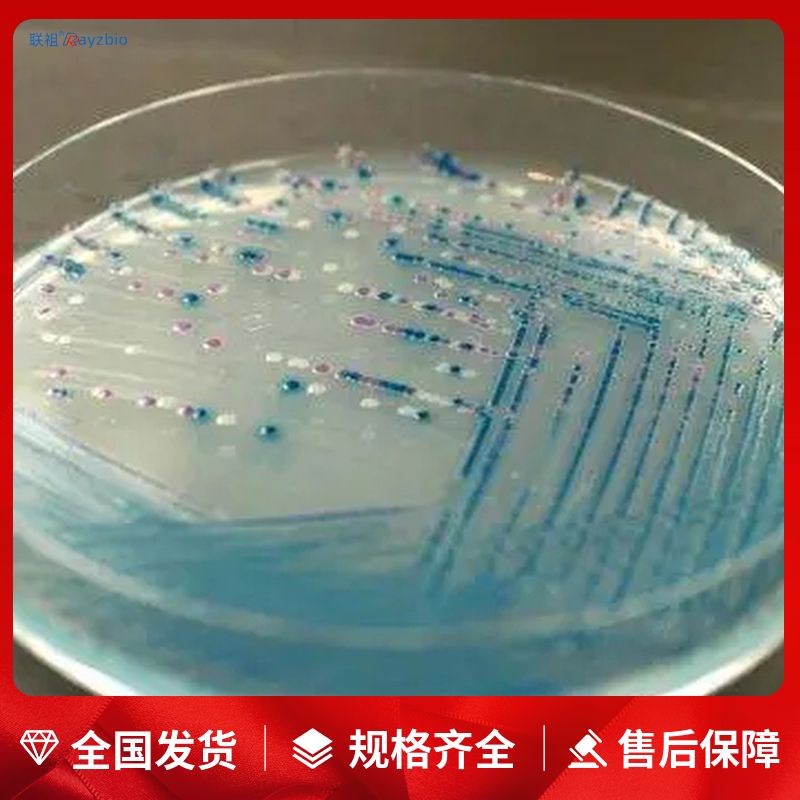
产品封面图

相关产品推荐更多 >
万千商家帮你免费找货
0 人在求购买到急需产品
- 详细信息
- 文献和实验
- 技术资料
- 库存:
53
- 供应商:
上海联祖
- 规格:
500mL
中文名称:MT培养基(含蔗糖)
英文名称:见说明
产品规格:500mL
发货周期:1~3天
产品价格:询价
| 货号 | 规格 | 发货期 | 用途 |
| LZ-PYJ3498 | 500mL | 1~3天 | 仅供科研实验 |
MT培养基(含蔗糖)主要由钾盐、氯化钙、硫酸镁、磷酸盐等组成,钾盐工作浓度为1650mg/L、硫酸镁工作浓度为370mg/L、肌醇工作浓度为100mg/L。该试剂特点是维生素含量较高,盐和硫胺素含量较高,经高压灭菌,为无菌溶
保存条件:4℃,6个月
培养基操作步骤:
一、用法:称取本品33.0g,加热溶解于1000ml蒸馏水中,分装三角瓶,121℃高压灭菌15分钟,备用。
二、配料:首先,根据培养基的配方,准确称量各种成分,包括粉状和非粉状的成分,如肉膏等,放入烧杯中。
三、溶化:向烧杯中加入适量的水,然后搅拌以溶解各成分。对于含有琼脂的培养基,应注意防止外溢,并在溶化过程中保持搅拌。
四、矫正pH:在培养基溶解均匀并冷却至室温后,使用pH试纸测量pH值,然后根据需要加入酸或碱来调整至合适的pH值。
五、澄清过滤:使用滤纸或多层纱布对培养基进行过滤,以去除杂质。
六、分装:将制备好的培养基分装入试管内或三角瓶内,确保管(瓶)口塞上棉塞,以防止外界微生物污染。
七、灭菌:对分装好的培养基进行灭菌处理,通常是通过高压灭菌来确保无菌环境。
八、检定:灭菌后的培养基可以进行质量检定,以确保其符合使用要求。
培养基的计数方法:
一、稀释涂布平板法(亦称活菌计数法)是一种常用的微生物计数方法,其原理是当样品的稀释度足够高时,培养基表面生长的一个菌落来源于样品稀释液中的一个活菌。通过统计平板上的菌落数,可以推测出样品中大约含有多少活菌。这种方法操作简便,适用于菌体大小和质量都相近的类群,如细菌、酵母菌等的计数。计算公式为每克样品中的菌株数=C/V*M,其中C代表某一稀释度下平板上生长的平均菌落数,V代表涂布平板时所用的稀释液的体积(mL),M代表稀释倍数。
二、显微镜直接计数法利用特定细菌计数板或血细胞计数板,在显微镜下计算一定容积的样品中微生物数量。这种方法不能区分死菌与活菌,但可以估算出1mL培养中液中细胞个数,计算公式为1mL 培养中液中细胞个数=小方格中细胞平均数×400 ×104×稀释倍数(个/mL)。显微镜直接计数法的缺点是不能区分死菌与活菌,因此计数到的细胞数包括了死亡的细胞数。
公司正在出售的产品:
冰冻切片组织TNF ALPHA蛋白表达NBT显色光学显微镜检测试剂盒
石蜡切片组织TNF ALPHA蛋白表达NBT显色光学显微镜检测试剂盒
细胞TNF ALPHA蛋白表达比色法定量检测试剂盒
细胞TNF ALPHA蛋白表达荧光定量检测试剂盒
TNF ALPHA蛋白表达西方杂交分析试剂盒
Human Recombinant Multimerin 1 ELISA Kit,Recombinant Multimerin 1,MMRN1
Human alpha-1-B Glycoprotein ELISA Kit,alpha-1-B Glycoprotein,α1BG
Human apoprotein H ELISA Kit,apoprotein H,apo-H
Human receptor tyrosine kinase ELISA Kit,receptor tyrosine kinase,RTKs
Human fucosyltransferase 2 ELISA Kit,fucosyltransferase 2,FUT2
STXBP1 Antibody (Clone#23S96) 人棕榈酰化膜蛋白2ELISA试剂盒
OSGEP Antibody (Clone#OTI8B3) 人结缔组织活化肽ⅢELISA试剂盒
GNAQ Antibody (Clone#30G74) 人白介素3受体αELISA试剂盒
DPF2 Antibody (Clone#27D77) 人抑制素β-BELISA试剂盒
MYST2/KAT7 Antibody 人胸肾表达趋化因子ELISA试剂盒
DDX6 Antibody (Clone#8G6) 人轴突生长诱向因子4ELISA试剂盒
RNF4 Antibody (Clone#OTI9F10) 人神经肽Y受体Y1ELISA试剂盒
Haptoglobin/HP Antibody 人多巴胺转运蛋白ELISA试剂盒
CD39/ENTPD1 Antibody 人膜联蛋白A6ELISA试剂盒
MYL4 Antibody (Clone#OTI1H6) 人丝蛋白酶1ELISA试剂盒
RASSF8 Antibody (Clone#OTI1F5) 大鼠apelin 12ELISA试剂盒
MTAP Antibody (Clone#28M98) 大鼠白细胞介素2ELISA试剂盒
SIL1 Antibody (Clone#OTI3B11) 大鼠多巴胺D1受体ELISA试剂盒
SCML2 Antibody (Clone#OTI1E1) 大鼠环磷酸腺苷ELISA试剂盒
SUB1 Antibody (Clone#6B5B10) 大鼠抗核膜糖蛋白210抗体ELISA试剂盒
HLA-A Antibody (Clone#OTI4D11) 大鼠ELISA试剂盒
ORAI3 Antibody (Clone#2H2G9) 大鼠糖化血红蛋白A1cELISA试剂盒
PCTAIRE1/CDK16 Antibody (Clone#29C70) 大鼠血管生成素2ELISA试剂盒
Arjunetin
Malvidin chloride
MT培养基(含蔗糖)D-甘露醇发酵管(枯草芽孢杆菌) 20支
溶菌酶肉汤基础 Lysozyme Broth Base 250g
多粘菌素B(1万单位) Polymyxin B 1万单位*5支
如何配置培养基:
1、配制溶液
向容器内加入所需水量的一部分,按照培养基的配方,称取各种原料,依次加入使其溶解,最后补足所需水分。对蛋白胨、肉膏等物质,需加热溶解,加热过程所蒸发的水分,应在全部原料溶解后加水补足。
2、调节pH值
用pH试纸(或pH电位计、氢离子浓度比色计)测试培养基的pH值,如不符合需要,可用10%HCl或10%NaOH进行调节,直到调节到配方要求的pH值为止。
3、过滤
用滤纸、纱布或棉花趁热将已配好的培养基过滤。用纱布过滤时,最好折叠成六层,用滤纸过滤时,可将滤纸折叠成瓦棱形,铺在漏斗上过滤。
4、分装
已过滤的培养基应进行分装。如果要制作斜面培养基,须将培养基分装于试管中。如果要制作平板培养基或液体、半固体培养基,则须将培养基分装于锥形瓶内。
5、加棉塞
分装完毕后,需要用棉塞堵住管口或瓶口。堵棉塞的主要目的是过滤空气,避免污染。棉塞应采用普通新鲜、干燥的棉花制作,不要用脱脂棉,以免因脱脂棉吸水使棉塞无法使用。
6、制作斜面培养基和平板培养基
培养基灭菌后,如制作斜面培养基和平板培养基,须趁培养基未凝固时进行。
风险提示:丁香通仅作为第三方平台,为商家信息发布提供平台空间。用户咨询产品时请注意保护个人信息及财产安全,合理判断,谨慎选购商品,商家和用户对交易行为负责。对于医疗器械类产品,请先查证核实企业经营资质和医疗器械产品注册证情况。
文献和实验含梗率是指烟梗在烟叶中所占的质量分数(%)。烟叶的含梗率受烟叶的类型。品种、烟叶所生长的部位、叶片形状和厚度、梗的粗细等影响。不同品种烟叶含梗率关系为烤烟>白肋烟>香料烟。烤烟含梗率在24-30%,平均为25%,左右。烟叶着生部位不同,含梗率也不同,,中下部叶高于上部叶。由于烟叶从叶基到叶尖,烟梗由粗逐渐变细,打叶复烤工艺利用这一特点,可在打叶前设置切尖工序,以降低打叶设备负荷和减少叶片造碎,提高大中片合格
南京大学医学院附属鼓楼医院内分泌科毕艳教授团队和南京大学生命科学学院张辰宇、李靓教授团队合作,首次发现外泌体可介导脂肪-大脑间通讯并促进糖尿病认知功能障碍的发生。研究成果发表在国际著名期刊《Cell Metabolism》上。研究背景:糖尿病显著增加认知障碍的发生风险,严重影响老年人健康生存状态。临床研究表明控制血糖不能保护认知功能,因此需要进一步揭示糖尿病认知功能障碍的机制,寻找治疗糖尿病认知障碍的新策略。脂肪组织外泌体作为新型脂肪因子,可参与脂肪组织与其他外周组织器官间的生物
Notes: The key variable in MT spindown experiments is ATP. Under high ATP conditions,conventional MAPs are selectively co-sedimented with microtubules. In theabsence of ATP (or in presence of AMPPNP which induces rigor binding
技术资料暂无技术资料 索取技术资料